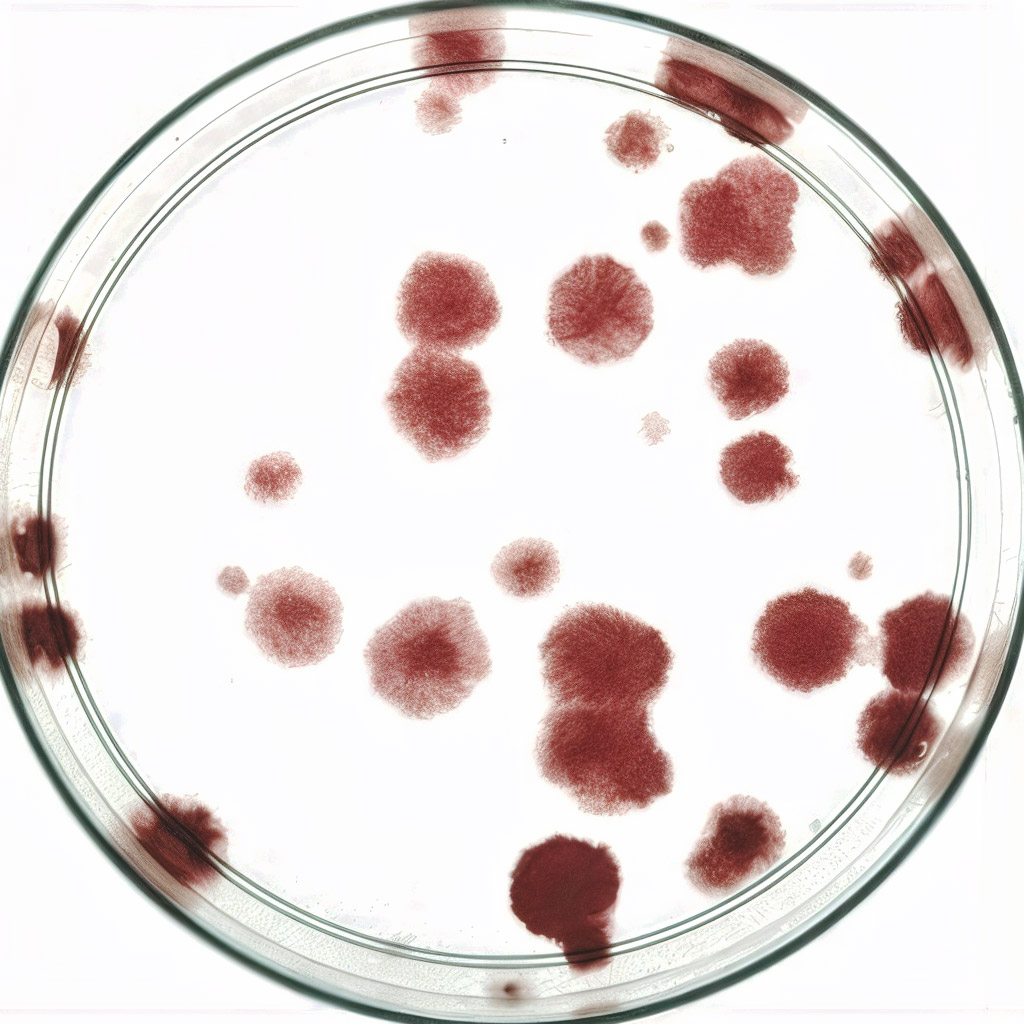
Vetrino

2018 – 4 Maggio
Questo è il nostro numero zero e qui vi presentiamo l’iniziativa intervistando il Dott. Claudio Zorzi che ringraziamo di cuore per l’attenzione che ha rivolto verso questo progetto e per la […]

2018 – 4 Maggio
Questo è il nostro numero zero e qui vi presentiamo l’iniziativa intervistando il Dott. Claudio Zorzi che ringraziamo di cuore per l’attenzione che ha rivolto verso questo progetto e per la […]

2018 – 18 Giugno
Eccoci alla prima uscita di Lettere di Ortobiologia. Ed eccoci a raccontarvi in un’uscita monografica il nostro incontro con il Prof. Philippe Hernigou, da tutti riconosciuto come uno dei […]
2018 – 18 Giugno
Eccoci alla prima uscita di Lettere di Ortobiologia. Ed eccoci a raccontarvi in un’uscita monografica il nostro incontro con il Prof. Philippe Hernigou, da tutti riconosciuto come uno dei […]
Questo sito utilizza cookie tecnici e di profilazione.
Puoi accettare, rifiutare o personalizzare i cookie premendo i pulsanti desiderati.
Chiudendo questa informativa continuerai senza accettare.
Impostazioni privacy
Questo sito utilizza i cookie per migliorare la tua esperienza di navigazione su questo sito.
Visualizza la Cookie Policy Visualizza l'Informativa Privacy
Google Analytics è un servizio di analisi web fornito da Google Ireland Limited (“Google”). Google utilizza i dati personali raccolti per tracciare ed esaminare l’uso di questo sito web, compilare report sulle sue attività e condividerli con gli altri servizi sviluppati da Google. Google può utilizzare i tuoi dati personali per contestualizzare e personalizzare gli annunci del proprio network pubblicitario. Questa integrazione di Google Analytics rende anonimo il tuo indirizzo IP. I dati inviati vengono collezionati per gli scopi di personalizzazione dell'esperienza e il tracciamento statistico. Trovi maggiori informazioni alla pagina "Ulteriori informazioni sulla modalità di trattamento delle informazioni personali da parte di Google".
Luogo del trattamento: Irlanda - Privacy Policy
Consensi aggiuntivi:
Google Fonts è un servizio per visualizzare gli stili dei caratteri di scrittura gestito da Google Ireland Limited e serve ad integrare tali contenuti all’interno delle proprie pagine.
Luogo del trattamento: Irlanda - Privacy Policy
Google Maps è un servizio di visualizzazione di mappe gestito da Google Ireland Limited. Questo servizio serve ad integrare tali contenuti all’interno delle proprie pagine.
Luogo del trattamento: Irlanda - Privacy Policy
Google reCAPTCHA è un servizio di protezione dallo SPAM fornito da Google Ireland Limited.
L'utilizzo del sistema reCAPTCHA è soggetto alla privacy policy secondo termini di utilizzo di Google.
Luogo del trattamento: Irlanda - Privacy Policy
Joint S.r.l. - Via Giovanni Felisati 1/3
370171 - Mestre VE - Italy
Tel. +39 041.93.33.50
P.IVA e C.F. 03116230278
Via Fagarè 21 - 30171 Venezia Mestre
REA: 282146 - Reg. Imp. VE 03116260278
Cap. Soc. 50.000,00€
Codice Unico: M5UXCR1
Rimani connesso con l’innovazione Joint: iscriviti alla nostra newsletter per ricevere approfondimenti tecnici e novità esclusive direttamente nella tua casella email.
Entra a far parte del nostro network professionale.
Riceverai solo aggiornamenti di valore, senza spam.
Questo sito contiene informazioni destinate esclusivamente a medici, farmacisti e altri professionisti della salute, in conformità al D.Lgs. 24 febbraio 1997, n. 46 e successive modifiche.
Per proseguire, ti chiediamo di dichiarare la tua qualifica:
Sei un operatore sanitario?